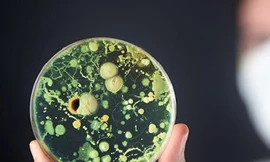
Siêu khuẩn nguy hiểm mới đang lây lan

Siêu khuẩn nguy hiểm mới đang lây lan
Candida auris là một loài siêu khuẩn mới, với tốc độ lây lan nhanh và khó nhận biết. Để dập tắt sự lây lan, các nhà khoa học đang cố gắng tìm ra cách phát hiện sớm siêu khuẩn này.
Candida auris là một loài siêu khuẩn mới, với tốc độ lây lan nhanh và khó nhận biết. Để dập tắt sự lây lan, các nhà khoa học đang cố gắng tìm ra cách phát hiện sớm siêu khuẩn này.
